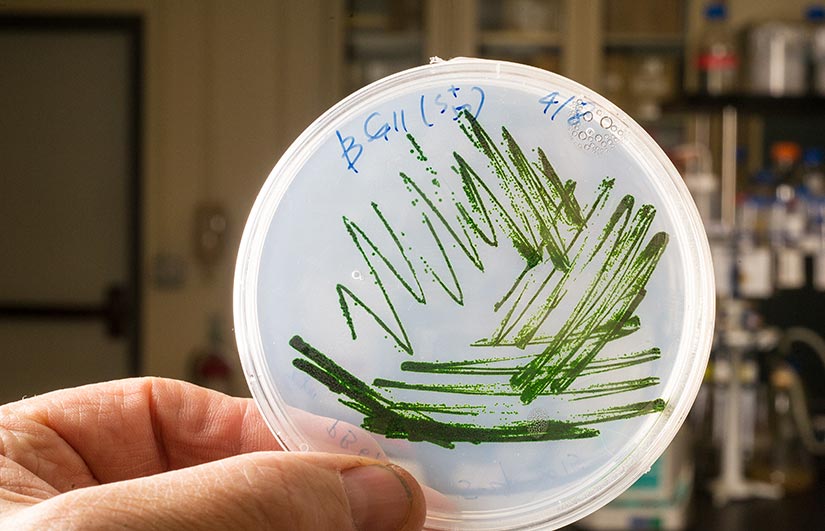

Grid Modernization News
Explore our archive of grid modernization news stories.
Forget Sci-Fi—This NREL Biotechnology Could Actually Help Colonize Mars
In the Push To Settle the Red Planet, One Startup Company Thinks NREL’s Ethylene-Emitting Cyanobacteria Offer Otherworldly Potential
Microbial Workhorses—NREL’s patented cyanobacteria (pictured) are engineered to emit ethylene as a byproduct of routine photosynthetic processes. Photo by Dennis Schroeder, NREL
Do not expect to breathe freely in the oxygen-lean Martian air. At about 95% carbon dioxide (CO2) by volume, Mars' atmosphere would quickly lead to asphyxiation, at least without supplemental oxygen.
Not so for cyanobacteria, photosynthetic microbes that thrive in CO2-rich environments—be it the cold, distant atmosphere of Mars or on Earth in a tank pumped with off-gas from a biofuel refinery. Scientists are working on harnessing this quality to convert growing concentrations of CO2 in Earth's atmosphere into the same chemicals currently made from petroleum and natural gas—a step toward decarbonizing the chemical industry.
So, if earthlings can use cyanobacteria to make chemicals on planet Earth—how much more might they offer astronauts with access to Mars' abundant CO2?
That is a question National Renewable Energy Laboratory (NREL) scientists and partner Nzyme2HC are actively pursuing after signing an agreement to explore whether astronauts can use NREL's patented ethylene-emitting cyanobacteria in closed systems to manufacture building materials on Mars.
"The red planet has what we need to make ethylene, and that ethylene can be used to make all sorts of materials," said Eric Payne, a senior licensing executive for NREL technologies. "When future astronauts successfully land on Mars, could they use NREL's cyanobacteria to make what they need to build a colony? NREL and Nzyme2HC are working to find that out."
For Earthlings: Safe Drinking Water, Reduced Emissions

Even just a few years ago, making ethylene from anything but petroleum or natural gas may have seemed about as distant as Mars itself.
Ethylene is the most widely produced petrochemical globally and is the main ingredient for a wide range of plastics and commodities. For every ton of ethylene produced during that process, as much as three tons of CO2 is released into the atmosphere.
But an exciting alternative route for making ethylene emerged in 2012 after NREL biologist Jianping Yu discovered how to insert an extra enzyme into a certain strain of cyanobacteria. It allowed the organisms to emit ethylene gas while metabolizing sunlight, water, and CO2.
"The chemical industry emits a lot of CO2," Yu said. "The goal with our bioethylene technology was to produce liquid transportation fuels from CO2 using ethylene as an intermediate. The technology can potentially help the chemical industry reduce carbon emissions, even sequestering it in long-lasting materials such as PVC pipes to replace lead pipes and provide safe drinking water."
The breakthrough, supported by the U.S. Department of Energy (DOE) Bioenergy Technologies Office, earned Yu and his team a prestigious R&D 100 Award, a so-called "Oscar of innovation." It also captured the attention of startup company Nzyme2HC, which saw potential in the patented biotechnology while working with NREL as part of a DOE small business research agreement.
"We're all well aware of the challenges some communities are facing in terms of lead in drinking water," said Nzyme2HC CEO Steve Cardona. "Our company saw the practical value of NREL's technology to make affordable, long-lasting, and safe pipes to offset that issue, while also offering a solution to address climate change."
Fed CO2-rich off-gases from industrial processes, the cyanobacteria could help nullify emissions from powerplants or refineries, turning carbon emissions into ethylene instead. A zero-emission alternative for producing ethylene from greenhouse gases in Earth's atmosphere was at hand.
For Cardona and his colleagues, that achievement made Mars appear closer, too. Could NREL's ethylene-emitting cyanobacteria give scientists the keys for establishing worlds beyond?
For Martian Astronauts: Oxygen, Building Materials for Setting Up Base

Consider for a moment the tricky logistics of colonizing Mars. With little oxygen in its atmosphere, colonists would need a way to make it from scratch or else be limited by the capacity of an oxygen tank. They would also need a way to easily use resources on the planet as materials to build houses, farms, and research facilities.
However you look at them, those challenges can translate into eye-popping price tags for colonizing the red planet.
"In theory, NREL's ethylene-producing cyanobacteria could solve both challenges," Cardona explained. "Ethylene is the basic building block for all kinds of plastics. It can be polymerized for high-density polyethylene and coupled with 3D printing to produce custom building components."
Bathing in the Martian sunlight and pumped full of the planet's CO2-rich air, closed cyanobacterial farms could supply a stream of ethylene for a range of building materials. During that photosynthetic process, they would also release oxygen, which colonists could capture and store.
In other words, NREL's organisms could offer a solution for two fundamental needs of any healthy human community: shelter and fresh air.
To explore the numerous factors for realizing that vision, Cardona and his Nzyme2HC colleagues are working with Explore Mars Inc., a nonprofit with a mission to achieve human exploration of Mars by the 2030s. Their goal is to explore technologies that can be used by NASA for missions to Mars—technologies like ethylene- and oxygen-emitting microorganisms.
NREL Innovation Fuels Entrepreneurship—Both on Earth and Off
Through the new agreement with NREL, Nzyme2HC has optioned rights on the biotechnology to explore commercialization and partnering scenarios, according to Payne.
"We love working with industry and research partners because it is a step toward getting beneficial emerging technologies into the real world," he said. "I think this is a great example of how entrepreneurs can creatively retool NREL innovations to expand the realm of the possible."
For Yu, whether NREL's ethylene-emitting cyanobacteria enable humans to colonize Mars or merely help secure safe drinking water on earth, both projects reveal the transformational potential of the technology.
"We see broad application of these cyanobacteria in making chemical manufacturing more sustainable," Yu added. "If the technology can help build homes on Mars, that's beyond my dream."
Learn how to partner with NREL or license its transformational bioenergy technologies.
Share
Last Updated March 10, 2025